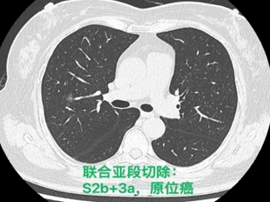
11A6B

科室简介
科室简介1986年,在普通外科老一代专家的帮助下,胸心外科在普通外科成立了专业组,周冠汉教授担任首位学科带头人。周冠汉教授为新中国第一批公派医学13人访美团成员之一,为科室的创建呕心沥血,从人员安排,技术力量培养,床位的设置,专业仪器的添置,病人的来源等方面做了大量的工作。从1986年9月第一例贲门癌根治术开始,历经5年时间,科室年手术量增加至100台次。

1991年,根据胸心外科发展的需要,胸心外科独立建科。刘丹丹医生代理科室主任,带领全科同志继续 在本学科领域里,不断探索,深入研究,开拓进取,积极工作。作为国内第一批开展胸腔镜业务的单位之一,1994年3月,科室成功实施第一例胸腔镜下肺大泡切除术。1995年开展首例经腹食管裂孔疝的胸腔镜手术,同期成功开展了袖状肺切除术。随着时间推移,科室业务发展逐渐趋于多元化、高端化及复杂化,为后续科室继续发展奠定了坚实的基础。

根据全院医疗形势的发展需要,2000年胸外科引进学科骨干和学术带头人,中国协和医科大学肿瘤学院胸外科博士闫天生主任医师担任科主任,胸外科由此进入快速发展阶段。学科特色定位为“胸部肿瘤与微创手术两翼齐飞”,同时以“科有特色、人有专长”的思路建立和发展学科队伍。在胸部肿瘤和胸部微创手术方面,紧跟国际和国内前沿治疗技术和理论,大力开展新技术,推动学科的强势发展。业务上开展了主支气管及叶支气管袖式肺叶切除治疗肺癌、气管袖式切除治疗气管肿瘤、VATS肺减容手术治疗重度肺气肿、VATS肺叶切除术、VATS治疗手汗症、VATS胸腺扩大切除术治疗高老龄重症肌无力、右开胸一切口高位食管癌切除超胸顶吻合术、手辅助胸腔镜食管癌切除左胸弓上吻合术等技术,使胸外科进入了一个崭新的微创时代。
2013年胸外科人才梯队建设进一步强化,闫天生主任由北京肿瘤医院引进马少华副主任医师,科室力量得到进一步壮大。同年开展了胸腹腔镜联合食管癌根治术,效果良好,截止目前累计已达150例,受到同行广泛认可。在VATS手术方面也有了进一步发展,规范化VATS单项式肺叶切除、开展VATS袖状切除术、VATS解剖性肺段切除术、sigle port VATS肺叶切除术,VATS全肺切除术、Hook Wire定位肺结节精确切除术等行业内先进技术,使得VATS技术进入了新的平台。同时召开北医三院胸外科微创论坛,累计15期,学员辐射全国,达600人次。目前科室在医、教、研三方面拟全面发展及提升,保证临床工作稳步前进的同时重点发展科研及临床转化研究,正朝着科研型科室的方向努力奋进!




前任北医三院胸外科行政主任
2022年12月,强光亮教授从国家呼吸医学中心、中日友好医院调入北医三院胸外科,主持工作以来,科室的工作有条不紊的开展,现有床位32张,年手术量超过1200台。年轻医生工作积极,手术技术日益成熟。同时,分院区手术陆续开展,现已开展北京大学第三医院延庆院区、秦皇岛院区胸外科手术,未来还将继续在北医三院其他分院区开展手术,科室规模更上新台阶。
胸外科承担北京大学医学部临床教学工作,是临床医师规范化培训和胸外科医师专科培训基地,优质护理病房、加速康复外科(ERAS)示范病房。每年召开胸外科微创论坛,学员辐射全国。从基础到临床,科研工作不断展开,已有并申请多项专利,同时进行临床转化。
胸外科临床技术全面,几乎开展胸外科所有类别手术,并不断创新。是全国率先开展胸腔镜微创手术的一批单位,也是北京市较早开展机器人辅助手术的单位之一。
目前已经开展机器人辅助手术百余例。包括各种肺叶、肺段切除,肺袖状切除,食管癌切除及纵隔肿瘤切除。
常规腔镜方面,以胸部肿瘤外科为主,开展肺叶、肺段、复合肺段/亚段切除、解剖性肺切除、袖状切除等手术,包括单孔到多孔等各种入路。在北京市较早开展微创食管癌切除,积累了丰富的经验。纵隔肿瘤方面,开展包括剑突下及其他入路胸腺切除、胸腺扩大切除,无名静脉成型等。同时结合锚丝定位、术前三维重建技术和荧光腔镜技术使手术安全高效。
在非肿瘤外科方面,在气胸、复杂气胸的治疗,胸壁畸形的矫正,创伤性肋骨骨折内固定方面,胸外科也积累了丰富的经验。
践行先进的治疗观念,作为大型综合医院的一员,开展多科室协作,主导肺癌MDT。进行新辅助治疗及肿瘤病人的全程管理。对越来越多见的高龄合并症多的患者,提供个体化治疗方案。
科室特色
目前主流的胸外科微创手术业务我科已达到全覆盖。包括但不限于:胸腔镜下肺叶、肺段、亚段、联合亚段、全肺、肺袖状切除术;单孔胸腔镜微创手术,Hook-Wire定位小结节精准切除手术,微创胸腹腔镜联合食管癌切除术,剑突下纵隔肿物切除术,达芬奇机器人辅助各类手术等几乎所有的胸外科先进微创的手术方式。

单孔胸腔镜微创手术

三维重建达芬奇奇迹人辅助胸腔镜精准肺段切除术

支气管、肺动脉袖状肺叶切除术(双袖切)

沙滩椅位双侧交感神经

各类联合亚段切除术
由北医三院胸外科牵头成立的北医三院肺癌MDT团队组建于2013年,成员科室包括:胸外科、肿瘤化疗与放射病科、肿瘤放疗科、病理科、呼吸与危重医学科、核医学科、放射科、生物样本库、放射科。切实解决了临床的复杂问题。一站式服务,全程化管理,从影像初诊判断,到穿刺病理确诊;从绿色通道入院,到微创手术治疗;从术后辅助化疗,到序贯局部放疗,并连续多年获得院级答辩优秀团队。

胸外科牵头成立的肺癌多学科联合诊疗MDT团队
北医三院胸外科为ERAS术后快速康复示范病房。在ERAS理念的指导下,病人快速周转。另外,北医三院胸外科住院管理中心也在围手术期发挥了重要的作用。病人的术前检查与评估、合并症的专科会诊可以在住院前快速完成,减少了术前住院日,降低了手术风险.
北京大学第三医院肿瘤中心逐渐完善,标志着患者服务体系的进一步升级。在肿瘤中心的服务体系下,患者可以获得从体检筛查,到门诊就诊确诊,再到术前检查,取得肿瘤病理,最终制定治疗方案,进入各专科治疗的全套一站式服务。

胸外科全体医护
Copyright © 2022 北京大学第三医院 京ICP备05082115号-2